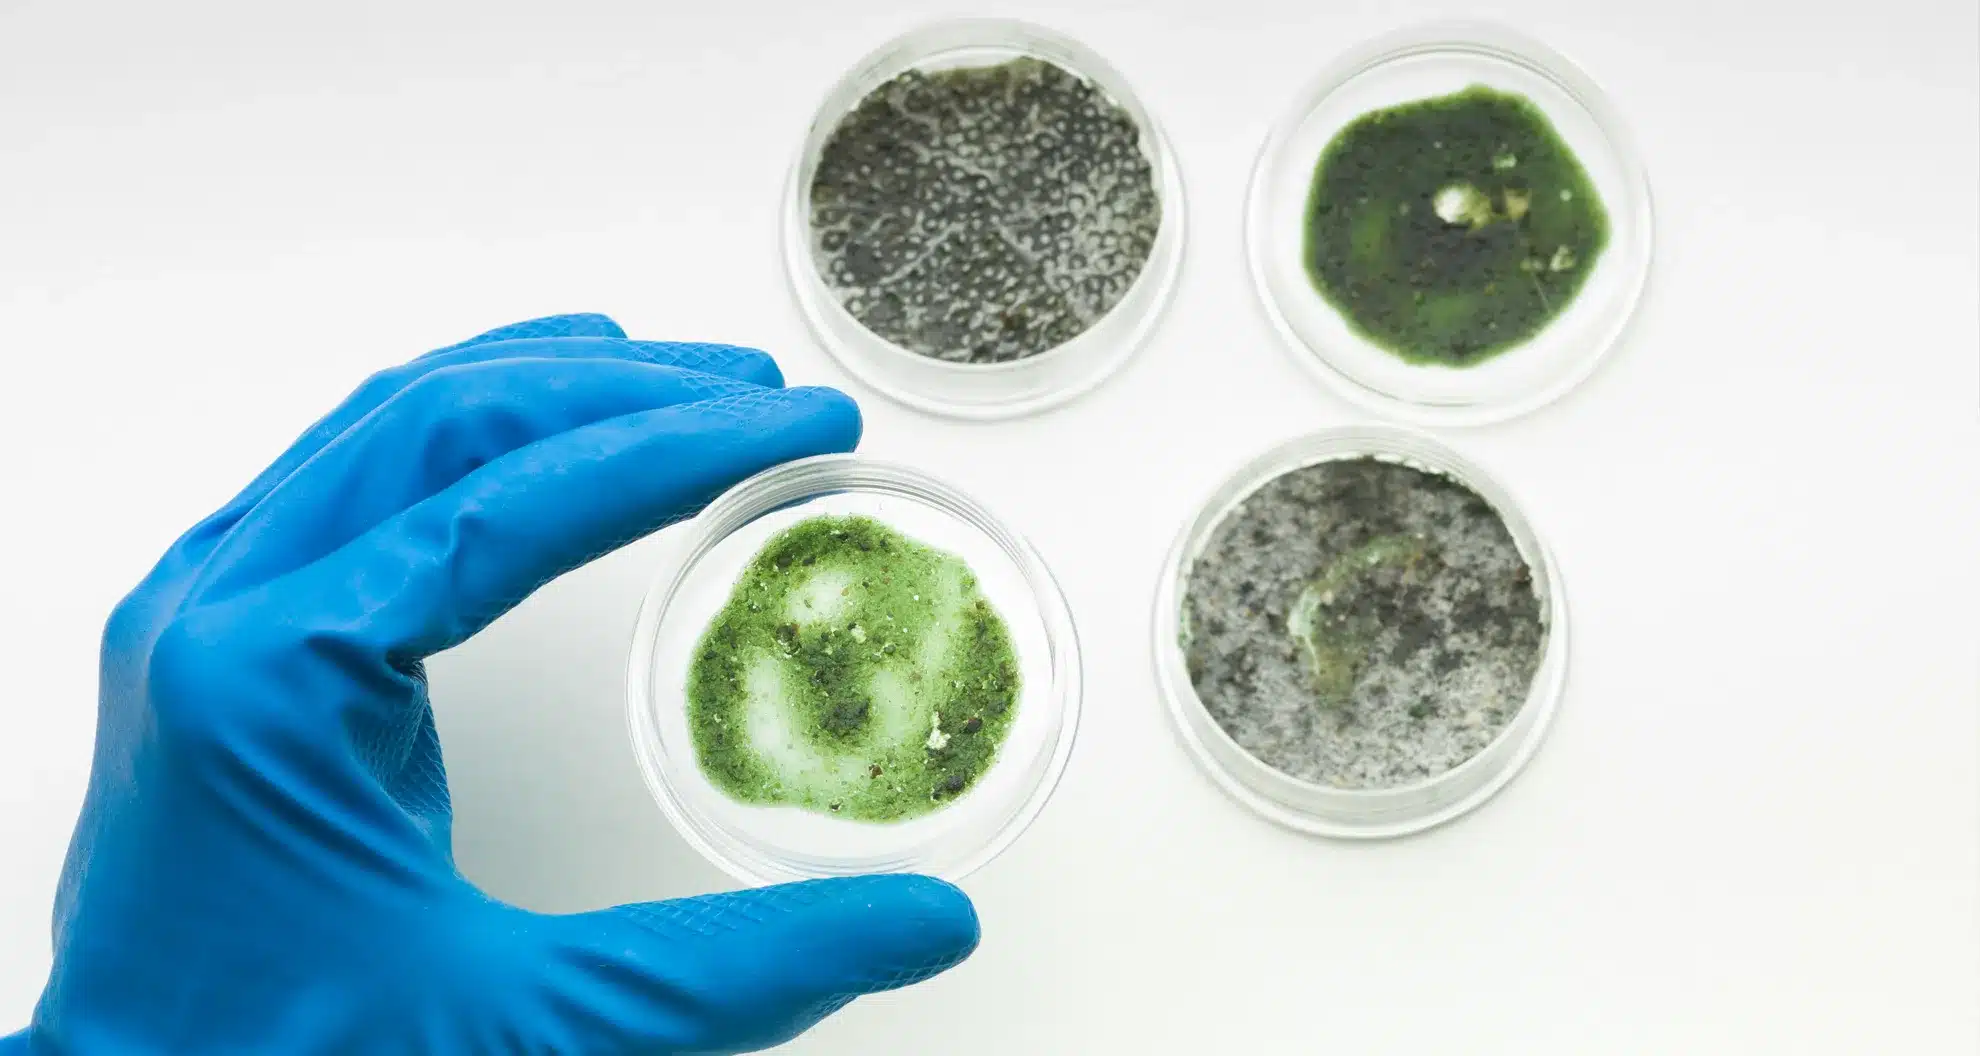

Mold is a common everyday part of life. Indeed, it can never be completely removed from home since it enters houses via open doors and windows and can even be found on clothing and pets. But it certainly can be controlled. At FastFix Restoration, we believe being aware and educated about mold and how it grows is essential for all homeowners.
Learning about how Mold grows
Mold growth can begin to occur relatively quickly under the right conditions. The exact time it takes for mold to grow can vary depending on several factors, including the type of mold, the presence of moisture, temperature, and the availability of organic materials for mold to feed on.
Here’s a general overview:
- Moisture: Mold spores are present in the air both indoors and outdoors, but they require moisture to start growing. If there is excess moisture or water damage in an area, mold can begin to grow within 24 to 48 hours.
- Temperature: Mold thrives in temperatures between 77°F (25°C) and 86°F (30°C), although it can grow at lower and higher temperatures as well, just at a slower rate. Warmer temperatures typically promote faster mold growth.
- Nutrient Source: Mold needs organic materials to feed on. Common sources include wood, paper, drywall, and fabrics. If these materials are present and moist, mold can start growing.
- Spore Availability: Mold spores are always present in the environment, and they can land on surfaces and wait for the right conditions to begin growing.
- Ventilation and Airflow: Poor ventilation and stagnant air can create conditions favorable for mold growth by allowing moisture to accumulate.
- Humidity: High humidity levels can promote mold growth even without a direct water source. Relative humidity levels above 60% are considered conducive to mold growth.
It’s important to note that not all molds are the same, and the time it takes for them to become visible can vary. Some molds grow rapidly and become noticeable within days, while others may take weeks or even months to become visible.
At Fast Fix, we believe preventing mold growth is essential for maintaining a healthy indoor environment.
To prevent mold, it’s crucial to control moisture, maintain proper ventilation, fix any water leaks promptly, and keep indoor humidity levels within an acceptable range.
If you have mold problems in the Los Angeles area, we are here to help you. Our mold remediation specialists will arrive at your property at your earliest convenience to inspect your house for mold and make a strategy to get rid of it.
We want this blog to not only offer our services but also educate and make you aware of what you can do to protect yourself, your family, and your home. Our work is guaranteed, and we provide mold removal, fire damage, and water restoration services in the following areas: Los Angeles, Beverly Hills, Santa Monica, Malibu, Pacific Palisades, Encino, Woodland Hills, Calabasas, Burbank, Sherman Oaks, and Bel Air.

[…] How Long Does It Take For Mold To Grow: Usually 48-72 hours. […]